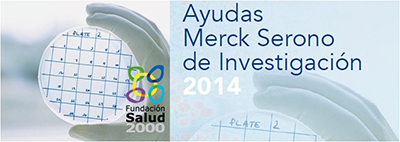

Plazo de presentación de las solicitudes: desde el 1 de marzo de 2015 al 20 de mayo de 2015, a las 19.00 h., hora peninsular.
AYUDAS FUNDACIÓN BBVA A EQUIPOS DE INVESTIGACIÓN CIENTÍFICA
Convocatoria 2015 · Biomedicina · Ecología y Biología de la Conservación · Humanidades digitales
Descarga de las bases completas de la convocatoria
1. PRESENTACIÓN La Fundación BBVA anuncia su convocatoria de ayudas a proyectos de investigación en las áreas de Biomedicina, Ecología y Biología de la Conservación y Humanidades digitales. Esta convocatoria responde al compromiso de la Fundación BBVA con el impulso de la investigación científica y la creación cultural, y su proyección a la sociedad, como forma de ampliar las oportunidades individuales y colectivas. El apoyo recurrente de la Fundación BBVA al desarrollo de la ciencia básica se complementa con esta convocatoria de ayudas dirigida a la realización de proyectos con un foco en áreas de alto interés social y actuación preferente de la Fundación BBVA, abarcando un abanico que incluye la investigación básica, la traslacional y la aplicada. Las áreas objeto de esta convocatoria son la Biomedicina, la Ecología y Biología de la Conservación y las Humanidades digitales.
2. ÁREAS Biomedicina: Las ayudas irán destinadas a proyectos de investigación altamente innovadores, de naturaleza básica, clínica o traslacional, exclusivamente en las áreas siguientes:
• Oncología
• Cardiología
• Enfermedades neurodegenerativas Ecología y Biología de la Conservación: Las ayudas se dirigen a proyectos de investigación susceptibles de ser aplicados a programas específicos de restauración y conservación de hábitats y/o especies amenazadas en España, preferentemente a ser desarrollados con colaboración significativa de organizaciones conservacionistas y/o agencias públicas en áreas de conservación del medio ambiente.
Las posibles aplicaciones del proyecto y/o el objeto y alcance de la colaboración con las mencionadas organizaciones y agencias deberán especificarse en la memoria del proyecto.
Humanidades digitales: Las ayudas se dirigen a proyectos del ámbito de las humanidades digitales que incorporen o aborden uno o más de los siguientes aspectos:
• La aplicación de las tecnologías de la información y de técnicas estadísticas para el tratamiento de objetos y cuestiones propias de las humanidades. • El estudio desde la perspectiva de las humanidades de los nuevos objetos electrónicos (nuevas narrativas y formatos, objetos digitales) y su significado cultural • El análisis desde la perspectiva de las humanidades de los efectos de internet en el plano de la cultura.
• La difusión innovadora, a través de la web, de los objetos y la producción propia de las humanidades.
3. DOTACIÓN Y PLAZOS DE EJECUCIÓN Biomedicina: Se concederá un máximo de 5 ayudas a la investigación. El importe bruto máximo de cada una de las ayudas (IVA incluido) será de 150.000 euros. El plazo máximo de ejecución de los proyectos será de 3 años. Ecología y Biología de la Conservación: Se concederá un máximo de 5 ayudas a la investigación. El importe bruto máximo de cada una de las ayudas (IVA incluido) será de 100.000 euros. El plazo máximo de ejecución con carácter general será de 2 años, extensible un año más previa justificación en el proyecto presentado. Humanidades digitales: Se concederá un máximo de 5 ayudas. El importe bruto máximo de cada una de las ayudas (IVA incluido) será de 60.000 euros. El plazo máximo de ejecución de los proyectos será de 2 años.
4. MODO Y PLAZO DE PRESENTACIÓN DE SOLICITUDES Las solicitudes deberán ser presentadas por el investigador principal, previa conformidad de la entidad universitaria o del organismo de investigación al que esté vinculado, utilizando únicamente la herramienta digital de remisión de solicitudes disponible en el sitio web de Fundación BBVA: www.fbbva.es Plazo de presentación de las solicitudes: desde el 1 de marzo de 2015 al 20 de mayo de 2015, a las 19.00 h., hora peninsular. Para más información: Esta dirección de correo electrónico está siendo protegida contra los robots de spam. Necesita tener JavaScript habilitado para poder verlo.

El Instituto de Especialidades Neurológicas D. Pedro Albert (IENSA), dedicado desde su fundación al tratamiento de las enfermedades del Sistema Nervioso, tanto central como periférico, ha considerado que debe colaborar en el avance del conocimiento de esta rama de la medicina, facilitando a otros especialistas en neurocirugía, neurología, neurofisiología, psiquiatría o neuropsicología la posibilidad de desarrollar y avanzar en cualquier área de las neurociencias.
El Instituto de Especialidades Neurológicas D. Pedro Albert (IENSA), dedicado desde su fundación al tratamiento de las enfermedades del Sistema Nervioso, tanto central como periférico, ha considerado que debe colaborar en el avance del conocimiento de esta rama de la medicina, facilitando a otros especialistas en neurocirugía, neurología, neurofisiología, psiquiatría o neuropsicología la posibilidad de desarrollar y avanzar en cualquier área de las neurociencias. La Asociación Española Familia Ataxia Telangiectasia (AEFAT) comunica la convocatoria de una beca de investigación. La beca va dirigida a licenciados menores de 30 años en Biología, Bioquímica, Farmacia, Física, Medicina o Química.
La Asociación Española Familia Ataxia Telangiectasia (AEFAT) comunica la convocatoria de una beca de investigación. La beca va dirigida a licenciados menores de 30 años en Biología, Bioquímica, Farmacia, Física, Medicina o Química.
 Neuron BioPharma convoca el premio a la mejor tesis doctoral en neurociencias, dotado con 3.000 Euros
Neuron BioPharma convoca el premio a la mejor tesis doctoral en neurociencias, dotado con 3.000 Euros